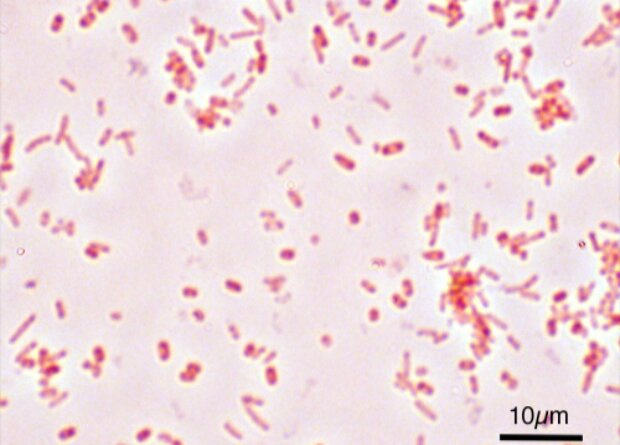

На Крите нашли 4000-летние случаи инфицирования чумной палочкой и сальмонеллой
Палеогенетики исследовали 68 человеческих зубов из пещеры Агио Хараламбоса, расположенной на Крите. Оказалось, что четыре индивида, жившие около четырех тысяч лет назад, были инфицированы чумной палочкой (Yersinia pestis) или сальмонеллой (Salmonella enterica). Филогенетический анализ показал, что геномы этих бактерий группируются с ныне исчезнувшими линиями, существовавшими в позднем неолите — бронзовом веке. Об этом сообщается в статье, опубликованной в журнале Current Biology.
Чума представляет собой инфекционное заболевание, вызываемое бактериями Yersinia pestis — зоонозными бактериями, как правило, присутствующими в организмах мелких млекопитающих и живущих на них блох. В прошлом чума вызывала масштабные пандемии с высоким уровнем смертности, самыми известными из которых выступают Юстинианова чума и Черная смерть. Долгое время считалось, что первые случаи заражения чумой произошли примерно три тысячи лет назад. Но в 2015 году генетики проанализировали ДНК 101 человека эпохи бронзы и выяснили, что семь индивидов были инфицированы чумной палочкой. Два самых древних на тот момент случая были выявлены у индивидов из Горного Алтая — представителей афанасьевской культуры, живших около 4800 лет назад. Но в минувшем году немецкие генетики обнаружили еще более ранний случай — чумной палочкой был инфицирован мужчина, живший более 5000 лет назад на территории современной Латвии.